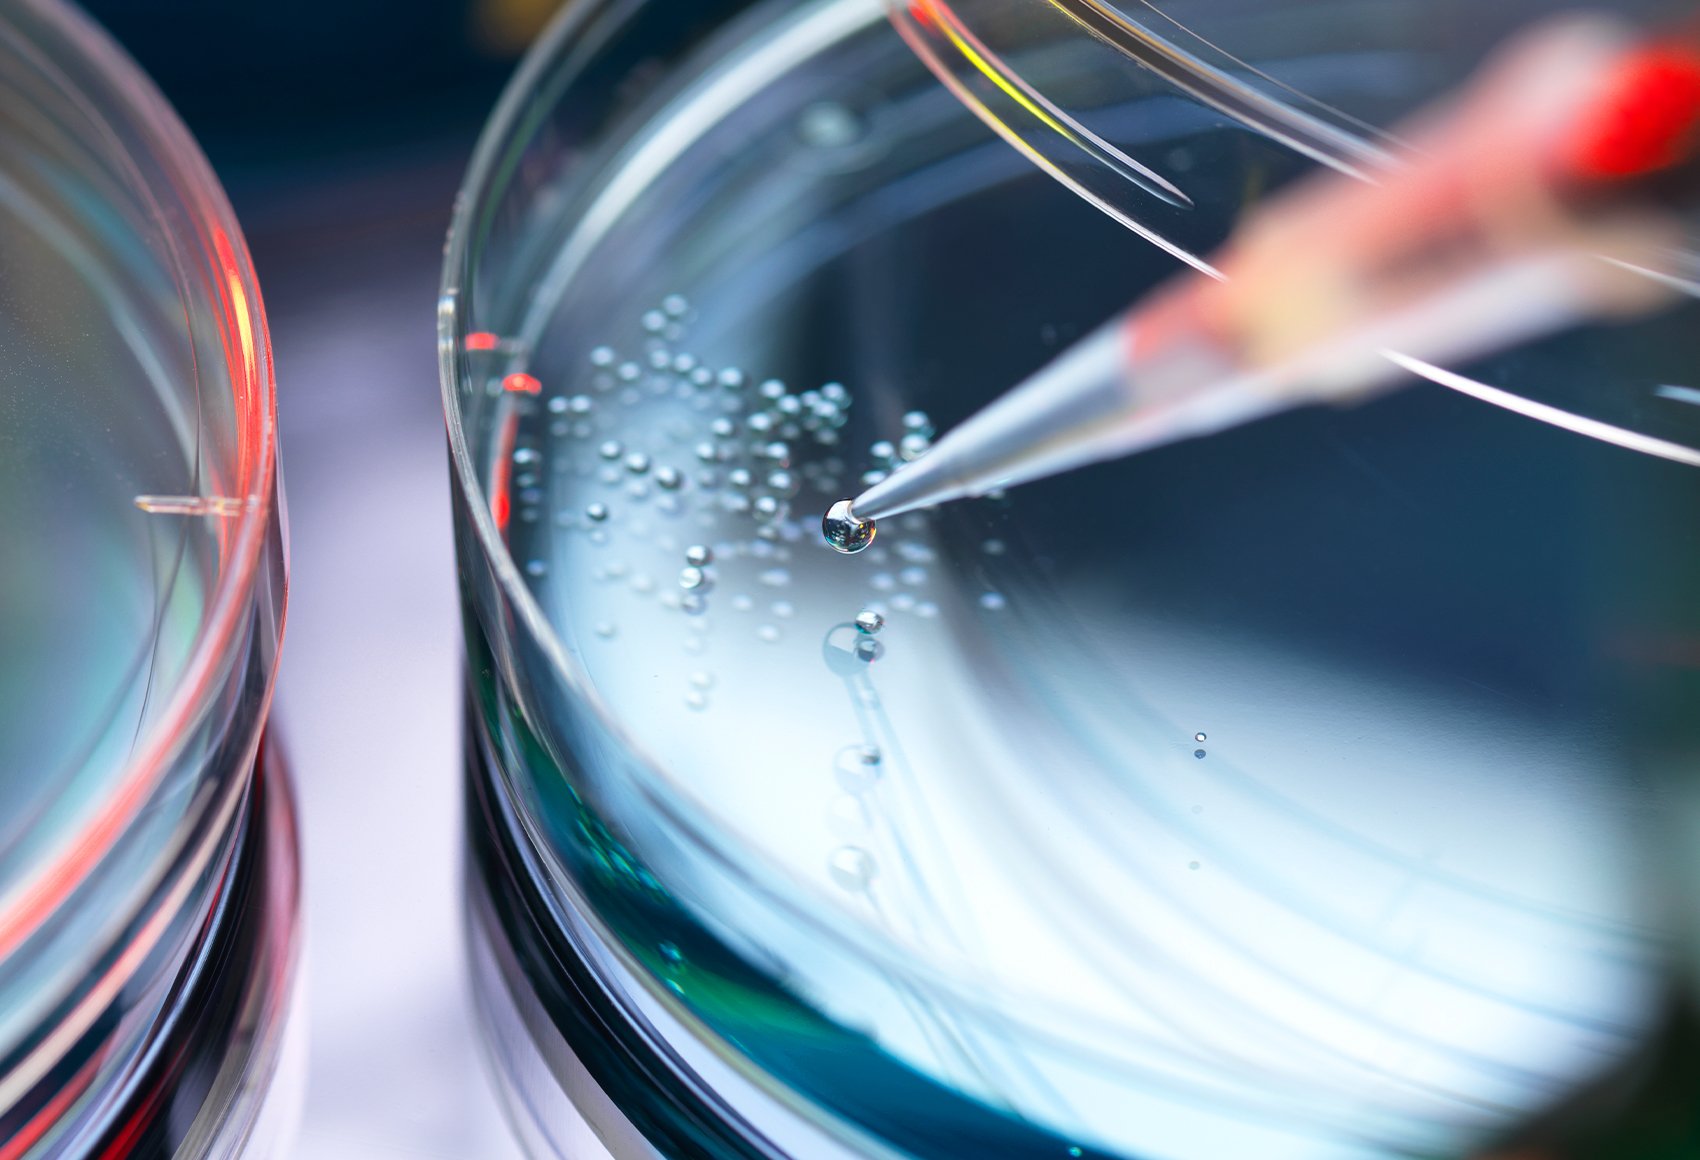
A close-up shot of a pipette dispensing a liquid onto a petri dish

Welcome to our ninth annual report on US securities class actions filed against publicly traded life sciences companies, which include pharmaceutical, biotechnology, medical device, and healthcare companies.
In the following sections, we analyze data and trends in securities class actions across all industries and in the life sciences industry in particular. We then highlight important 2024 decisions issued by federal courts in securities cases brought against life sciences companies and their officers.
Please reach out to the contacts listed below if you have questions or feedback or want to discuss how trends in the industry may affect your business.
Executive Summary
In the context of securities class action litigation, 2024 saw a return to long-term trends of increasing scrutiny and litigation against life sciences companies. Securities class action filings against publicly traded life sciences companies dropped in 2023 but came roaring back in 2024, jumping above the number of cases filed in 2022 or 2023 and reaching 40% above the average since 1997. Life sciences companies remain the biggest industry target for federal stockholder class actions.
While newly filed cases were at a high point, on the merits, court rulings continued to trend favorably for defendants throughout 2024, with courts dismissing the majority of observed cases. Several decisions highlighted the distinction between pure opinions or predictions of the future (which tend to be nonactionable) on the one hand, and statements of historical fact on the other. To survive challenges to their public statements, companies and their officers and directors need to maintain care when speaking about ongoing activities (e.g., revenue trends, clinical trial results, active discussions with the Food and Drug Administration, and active manufacturing challenges).
Context: Securities Class Actions Against Life Sciences Companies
Securities cases against publicly traded life sciences companies are typically filed by stockholders acting on behalf of a proposed class. Usually, the plaintiffs’ objective is to recoup alleged investment losses following a company’s stock price decline. In the context of life sciences companies, those swings in stock price often occur after the announcement of setbacks or issues related to a company’s drugs or products. Issues may include negative feedback or actions from the Food and Drug Administration (FDA); delays, suspensions, or terminations of clinical trials; unfavorable clinical data results; adverse events affecting patients; product recalls; or manufacturing or supply challenges. Plaintiffs typically assert claims under Sections 10(b) and 20(a) of the Securities Exchange Act of 1934 (the 1934 Act) and SEC Rule 10b-5, alleging that the company and its officers made false or misleading statements or failed to disclose material information. If the alleged misstatements or omissions are related to a registered securities offering, plaintiffs may bring their claims under Sections 11, 12(a)(2), and 15 of the Securities Act of 1933 (the 1933 Act) — often in addition to claims made under the 1934 Act.
Securities Class Action Filings in All Industries in 2024
In 2024, the number of new securities class action filings in federal and state courts increased to 225, up 5% from 215 in 2023, and up again from 2022.1 Total “core” filings increased to 220 in 2024, up from 209 in 2023, which represented the second year-over-year increase in a row.2 Securities class action filings continued to increase from their low point in 2022.
Notably, this growth in filings is driven entirely by securities class action cases bringing only Section 10(b)–related claims under the 1934 Act. In 2024, 198 core securities class action cases filed brought only Section 10(b)–related claims, the highest on record.3 The increase in federal 1934 Act cases more than made up for the decrease in state and federal cases brought under the 1933 Act, which fell from 32 filings in 2023 to only 21 filings in 2024.4 New core federal class actions related to special purpose acquisition company (SPAC) transactions also continued to fall from their peak of 33 cases in 2021, dropping to only 11 filings in 2024.5 As has been the case since their dramatic decline in 2021, M&A class action filings continued to fall in 2024, with only five such federal class action cases filed.6
Life Sciences Analysis: Securities Class Action Filings in 2024
Life sciences companies make up much of the consumer non-cyclical sector. New core federal filings in that sector rose in 2024 to 66, reversing a decrease in filings in 2023. That increase in filings came entirely from life sciences, with 52 filed securities class actions in 2024, up from 40 in 2023, and 40% higher than the long-run average from 1997 through 2023. As in years past, the consumer non-cyclical sector continues to represent the largest single sector for federal securities class action filings.7 The high volume of filings against life sciences companies in particular is likely due to the inherently volatile nature of their stock prices and the many event-driven disclosures made by such companies. That volatility likely drives the continued focus by the plaintiffs’ bar on life sciences companies. As shown in the chart below, the number of filings against companies in the life sciences industry in 2024 blew past the longer-term historical average and rose significantly when compared with 2023’s filings.

Securities cases against life sciences companies continue to be dismissed at about the same rate as other cases. As shown in the table below, 15% of federal core securities cases filed against pharmaceutical, biotechnology, and healthcare companies in 2023 were dismissed by the end of 2024 (with 77.5% of such cases still pending), and 42.2% of those cases filed in 2022 had been dismissed. This dismissal rate for cases pending for only one to two years is consistent with the long-term trend of about half of life sciences securities class actions being dismissed by the courts. The comparable number for all core federal filings was 20% of 2023 cases and 36% of 2022 cases.8 Consistent with previous years, the most significant federal circuits for life sciences securities class actions continue to be the First, Second, Third, and Ninth circuits.
Rulings in Securities Class Actions in 2024
As in previous years, we continue to focus on jurisdictions that have been the most active in securities class actions filed against life sciences companies: the First Circuit and District of Massachusetts; the Second Circuit, the Southern District of New York, and the Eastern District of New York; the Third Circuit, the District of New Jersey, and the Eastern District of Pennsylvania (added to this report in 2023); and the Ninth Circuit and the California District Courts. The Second and Ninth circuits still have the largest share of all cases, together accounting for 61% of all core federal class action filings (across all industries) in 2024, consistent with the long-term average from the 1997-to-2023 period.9 Following a spike in 2023, core federal filings in the Third Circuit reverted closer to the long-term mean in 2024.10
In 2024, federal courts in these key jurisdictions have continued to issue significant decisions in securities class actions concerning life sciences and healthcare companies in various growth stages, as well as their directors and officers. As in prior years, these cases involve challenges common to life sciences and healthcare companies, including negative clinical trial results, clinical trial delays, outcomes and discussions with FDA, supply and manufacturing issues, drug side effects, adverse events and other safety issues, product rollout, antitrust and regulatory compliance, M&A activity, and revenue projections. We highlight key decisions in each of these jurisdictions below.
While these decisions were largely favorable to defendants, some ruled in favor of the stockholder plaintiffs. Of the decisions resolving motions to dismiss, about two-thirds were favorable to defendants, but about one-third of the decisions denied the motion in whole or in part, allowing the case to proceed into the discovery phase and further litigation. Even of the favorable motion-to-dismiss decisions, more than one-third gave the plaintiffs an opportunity to replead their dismissed claims, continuing a trend in these jurisdictions — particularly within the Ninth Circuit — of giving plaintiffs leeway to amend their deficient pleadings multiple times. Overall, in the decisions, courts were skeptical of claims by plaintiffs challenging scientific opinions or forward-looking statements forecasting the potential future results of scientific research efforts. However, courts were more willing to deny motions to dismiss and allow claims to proceed into discovery if the plaintiffs could plead alleged misstatements concerning concrete facts (e.g., revenue trends in the current quarter or whether clinical trial enrollment had started).
[1] “Securities Class Action Filings — 2024 Year in Review,” Cornerstone Research (2025), at 1, 4.
[2] The number of “core” filings excludes cases filed in connection with an M&A transaction. Id. at 1. Removing M&A filings teased out the historic growth (and then decline) in that category of filings from 2014 through 2022. Id. at 4.
[3] Id. at 2.
[4] Id. at 4.
[5] Id. at 5.
[6] Id. at 3.
[7] Id. at 22.
[8] Id. at 16.
[9] Id. at 23.
[10] Id. at 23.
Securities 2024 Case Summaries
Zhou v. Desktop Metal, Inc., 120 F.4th 278 (1st Cir. 2024)
The plaintiffs alleged that Desktop Metal, Inc., and certain of its executive officers violated Sections 10(b) and 20(a) of the 1934 Act and SEC Rule 10b-5 by misleading investors concerning two products — a denture resin product (Flexcera) and a “curing box” product (PCA 4000) used to harden denture resin — manufactured and sold by one of the company’s subsidiaries. The plaintiffs alleged that certain statements concerning the products were rendered false and misleading by two separate fraud schemes. First, they alleged that Flexcera products were manufactured at facilities not registered with FDA and were later packaged using false labels. Second, they claimed Desktop Metal marketed PCA 4000 for use with Flexcera even though FDA had not certified it for that use. The plaintiffs also asserted a claim for scheme liability under Rule 10b-5(a) and (c) based on the same theories. The district court dismissed the plaintiffs’ claims, and the First Circuit affirmed the dismissal.
The First Circuit held that the challenged statements about FDA compliance related to Flexcera were not materially false and misleading. That Flexcera was manufactured at nonregistered facilities did not change the fact that it was nonetheless an FDA 510(k)–cleared product. Nor did production at nonregistered facilities render false or misleading the defendants’ statement that failure to comply with regulations “would have an adverse impact on [its] business and reputation.” That statement, the court reasoned, “is best understood as a cautionary statement, which disclaims full compliance rather than promises it.” And the generic statement that Desktop Metal was “adding capacity to meet the robust demand” for Flexcera was not rendered misleading by the failure to disclose that some Flexcera products were being manufactured by a nonregistered facility. Likewise, the First Circuit held that general statements about Flexcera’s qualities were not made false and misleading by the nondisclosure of the defendants’ sales strategy of promoting PCA 4000 for use with Flexcera because the plaintiffs failed to posit any plausible link between those statements and the supposed omission.
Finally, the First Circuit held that the plaintiffs did not preserve their scheme liability claims. When the defendants moved to dismiss in the district court, they “requested that the district court dismiss [the plaintiffs’] complaint in full.” But the plaintiffs never meaningfully addressed in their opposition why the scheme liability claims survived, nor did they move for reconsideration following the original dismissal of the case. And the First Circuit held that the plaintiffs’ one-sentence reference to the scheme liability claims at the motion to dismiss hearing did not fulfill the plaintiffs’ burden under general party presentation principles to “spell out” their argument for the district court.
Quinones v. Frequency Therapeutics, Inc., 106 F.4th 177 (1st Cir. 2024)
The plaintiffs alleged that Frequency Therapeutics, Inc., and certain of its executive officers violated Sections 10(b) and 20(a) of the 1934 Act after the company’s stock declined in the wake of its announcement that the Phase 2a trial for its FX-322 treatment for individuals suffering from hearing loss did not produce statistically significant results. The district court, however, dismissed the plaintiffs’ claims because they failed to allege sufficient facts to support a strong inference of scienter. On appeal, the First Circuit affirmed the dismissal, rejecting the plaintiffs’ argument that the defendants knew or “were reckless in ignoring signs that the Phase 2a trial might be infected with bias” when the challenged statements were made. First, the First Circuit held that confidential witness allegations — which claimed, among other things, that the chief development officer knew about a “discrepancy between certain patients’ responses during the screening process for admission into Phase 2a and subsequent examinations by the investigators” — failed to indicate when the officer learned of this discrepancy or explain why it would raise concerns in a double-blind trial. The First Circuit also found that the CEO’s sale of 15% of his shares during the alleged class period did not reduce his investment in Frequency by enough of a margin to allow for a strong inference of scienter. Finally, the First Circuit rejected the plaintiffs’ “core-operations” theory that the defendants must have known about the issues with the Phase 2a study because FX-322 was so important to the company, reasoning that the importance of a product alone does not provide a sufficient basis to determine when and what senior management were told about the product. Viewed in their totality, the First Circuit found that the plaintiffs’ allegations failed to paint a compelling picture of scienter, concluding that “while each individual fact about scienter may provide only a brushstroke, our obligation is to consider the resulting portrait. At the same time plaintiffs cannot amalgamate a series of sketchy brushstrokes and call it a van Gogh.”
Oklahoma Firefighters Pension and Retirement System v. Biogen Inc., 2024 WL 3178638 (D. Mass. Mar. 19, 2024)
The plaintiff alleged that Biogen Inc. and three of its executive officers violated the 1934 Act by making false and misleading statements relating to the commercial rollout of Aduhelm, a treatment for Alzheimer’s disease. The court originally dismissed the case in its entirety, citing the plaintiff’s mischaracterization of the challenged statements and the insufficiency of confidential witness allegations to establish that any of the challenged statements were actionable. Following the release of a Congressional investigation report (the House report) into the approval process of Aduhelm, the plaintiff moved to alter or amend that judgment with respect to three categories of challenged statements: statements concerning the readiness of sites to implement treatment of Aduhelm; statements concerning Biogen’s having “consulted” stakeholders regarding the allegedly high price of Aduhelm; and statements regarding the expected automatic presumption of Medicare coverage after FDA approval. The plaintiff claimed that the findings from the House report, as well as additional confidential witness testimony, constituted “new evidence” that warranted altering or amending the prior judgment and permitting the plaintiff to file a new amended complaint.
As an initial matter, the court rejected the plaintiff’s contention that any of the proffered evidence was truly “new.” Given the liberal amendment policy under the federal rules, however, the court analyzed whether the plaintiff nonetheless should have been permitted to amend its complaint. The court denied the plaintiff’s motion with respect to the first two sets of statements but granted the motion as to the third set of statements. With respect to the readiness statements, the court determined the new confidential witness allegations presented by the plaintiff amounted to “at best […] that the former employees ‘believed’” that the defendants were aware of the supposed readiness issues, not evidence that there were in fact readiness issues or that the defendants were aware of them. Similarly, the plaintiff’s new allegations drawn from the House report that Biogen consultants were told that payers found a price of $50,000 for Aduhelm to be excessive in fact indicated that Biogen had consulted stakeholders, not the opposite. However, the court also found that new allegations from the House report revealing that company management had discussed “the high likelihood that they would have a longer process and get narrower Medicare coverage for Aduhelm” were enough, at the pleading stage, to plead falsity and a strong inference of scienter with respect to the statements concerning Medicare coverage for Aduhelm.
Pizzuto v. Homology Medicines, Inc., 2024 WL 1436025 (D. Mass. Mar. 31, 2024)
The plaintiffs alleged that Homology Medicines, Inc., and certain of its executive officers violated Sections 10(b) and 20(a) of the 1934 Act and SEC Rule 10b-5 through supposedly misleading statements and omissions concerning the safety and efficacy of Homology’s gene therapy drug candidate, HMI-102. Specifically, the plaintiffs alleged that the defendants misled investors by disclosing favorable data from one set of patients in the trial while failing to disclose negative data from another set of patients; failing to disclose risks and deficiencies associated with a steroid regimen being administered to patients alongside the gene therapy dose; and creating a false impression that the available data supported advancing the drug to Phase 2 trials. The court dismissed the plaintiffs’ claims based on their failure to plead falsity, scienter, and loss causation.
The court found that the defendants’ first set of statements were not actionable because “companies reporting on clinical trial data may lawfully disclaim and defend their use of partial data and ‘cast their trial results in a positive light.’” The court also concluded that the plaintiffs failed to plead that any of the undisclosed patient data directly contradicted the disclosed data and the plaintiffs’ differing interpretation of the patient data was not a valid basis for a claim under the securities laws. As for the second set of challenged statements, the court found that the “total mix of information” showed that the defendants had sufficiently disclosed the risks and potential deficiencies associated with the company’s steroid regimen, such that the statements would not be false or misleading to a reasonable investor. And as for the statements related to the defendants’ hopes of progressing the drug to Phase 2, the court found they were nonactionable because they were statements of opinion and forward-looking statements accompanied by meaningful cautionary language that fell within the Private Securities Litigation Reform Act’s (PSLRA) safe harbor. The court specifically rejected the plaintiffs’ assertion that the defendants somehow knew the statements to be false because it was “implausible and conjectural” that the defendants would have proceeded to costly Phase 2 trials “while secretly believing” that the Phase 1 safety and efficacy data did not support it.
The court also held that the plaintiffs failed to adequately plead scienter because they relied on general allegations regarding the defendants’ supposed knowledge and motive but did not provide specific allegations that any of the defendants either knew their statements to be false or misleading or possessed a cognizable motive to defraud investors. Without more, the court found that the plaintiffs had failed to allege facts sufficient to give rise to a plausible inference of scienter. Last, the court held that the plaintiffs’ claims also failed because they did not point to a corrective disclosure connecting a stock drop to any of the alleged misstatements and thus did not adequately plead loss causation.
State Teachers Retirement System of Ohio v. Charles River Laboratories International, Inc., 2024 WL 3258293 (D. Mass. July 1, 2024)
The plaintiff alleged that Charles River Laboratories International, Inc., and two of its executive officers violated the 1934 Act by making misleading statements regarding its importation of nonhuman primates for drug development customers. The plaintiff alleged that, following U.S. Department of Justice (DOJ) investigations of certain nonhuman primate suppliers, Charles River made misleading statements about its supply chain and compliance with laws governing the import of nonhuman primates. The court dismissed all of the plaintiff’s claims. The court found that the defendants’ statements that it did not have a “direct” relationship with any of the indicted individuals or entities was literally true and that the plaintiff did not adequately allege otherwise. Likewise, the court found that the plaintiff’s complaint did not contain any allegations that contradicted the defendants’ statements about the company’s supply chain concentration. The court also concluded that the plaintiff’s allegations concerning Charles River’s supposed use of “non-preferred suppliers” were too vague to render the defendants’ statements false and misleading. For similar reasons, the court reasoned that the defendants’ statements concerning the quality and characteristics of the company’s primates and its inventory and the demand for the same were also not false and misleading. And the court held that the plaintiff failed to adequately allege that Charles River or any of its suppliers had actually violated the law — at best, the plaintiff alleged only that certain of the suppliers were under investigation. This too was insufficient to make any of the defendants’ statements about the company’s legal compliance or the “aspirational” statements in its codes of conduct false or misleading. In addition to finding that none of the challenged statements were actionable under the securities laws, the court also concluded that the plaintiff failed to establish scienter. The court rejected the plaintiff’s argument that the individual defendants’ alleged $67 million in stock sales during the class period supported an inference of scienter because there was nothing inherently suspicious about the timing and amount of their trades and the individual defendants’ total Charles River holdings had in fact increased over the course of the class period.
Brill v. Invivyd, Inc., 2024 WL 4228832 (D. Mass. Sept. 18, 2024)
The plaintiffs alleged Invivyd, Inc., and two of its officers violated Sections 10(b) and 20(a) of the 1934 Act and SEC Rule 10b-5 for making false and misleading statements regarding the projected efficacy of the company’s drug product ADG20 against the Omicron variant of COVID-19. While ADG20 had shown promise against initial strains of COVID-19, subsequent testing ultimately found a 300-fold reduction in its efficacy against Omicron. The court dismissed the plaintiffs’ claims in their entirety, concluding that the statements in question were all indications of the defendants’ subjective beliefs regarding ADG20 based on the information available to them at the time and that a reasonable investor would not expect the defendants to have conducted all possible analyses before offering their predictions. That the statements omitted warnings from public health officials that Omicron may be resistant to monoclonal antibodies such as the defendants’ product also did not render the statements materially misleading because “it is not a material omission to fail to point out information of which the market is already aware.” While the court noted that the defendants’ scientific opinions ultimately turned out to be wrong, it nevertheless held that there was no allegation that the facts underlying the defendants’ expressed beliefs were untrue or that they knew the statements were false when made. The court also held that the plaintiffs had not provided either direct or indirect evidence of scienter to support their allegations. The court found that the defendants had no conclusive evidence that ADG20 was ineffective against the Omicron variant when they made their statements, meaning their hedging, forward-looking statements regarding what they expected or anticipated the study results to show could not be considered highly reckless. The court also noted that the defendants were transparent when discussing the basis for their predictions, which undercut any allegations of recklessness. Finally, the court rejected the plaintiffs’ “fraud by hindsight” theory, finding that intent to defraud could not be inferred just from the fact that the in vitro results ultimately demonstrated that ADG20 was markedly less effective against Omicron.
DeKalb County Pension Fund v. Allergan PLC, 2024 WL 677081 (2d Cir. Feb. 20, 2024)
The plaintiffs alleged that Allergan plc and certain of its officers violated Sections 10(b) and 20(a) of the 1934 Act and SEC Rule 10b-5 for failing to disclose that its textured breast implant devices were associated with higher rates of a rare cancer — anaplastic large cell lymphoma (ALCL) — compared to textured devices produced by other manufacturers. The Second Circuit affirmed the district court’s grant of summary judgment in favor of Allergan and its executives, holding that a class of investor plaintiffs attempting to hold Allergan liable for alleged misstatements related to its textured breast implant devices failed to show any such statements were misleading. The plaintiffs challenged three statements, one from Allergan’s Form 10-K that referenced certain safety studies “suggest[ing] a possible association between [ALCL] and breast implants, as well as negative reports” issued by European regulators about an unaffiliated implant manufacturer; another from a press release regarding the safety profile of Allergan’s smooth and textured devices; and a third from a statement by Allergan published as part of a news article stating that ALCL “ha[d] been reported in patients with textured implants from all manufacturers.” The Second Circuit held that these statements were literally true, and not actionable as half-truths, because reasonable investors would not have been misled by these statements into thinking that Allergan’s textured products were not more closely associated with ALCL than the textured products of other manufacturers. In analyzing the statements, the court pointed to context such as the fact that the news article “acknowledged [that] the scientific community[]” had a “limited understanding” as to whether ALCL could be “tied to” devices from any “specific manufacturer[].” The Second Circuit also found that Allergan could not be liable under a “pure omission” theory because Allergan had no independent duty to disclose facts or opinions regarding the association between its textured breast implant products and ALCL.
Menora Mivtachim Insurance Ltd. v. Sheehan, 2024 WL 1613907 (2d Cir. April 5, 2024)
The plaintiffs alleged that Mylan N.V. and certain of its executive officers violated Section 10(b) of the 1934 Act and SEC Rule 10b-5 by making misleading statements because they failed to disclose, among other things, Mylan’s alleged participation in antitrust conspiracies related to the marketing of the EpiPen and alleged price-fixing arrangements related to several of the company’s generic drugs. The plaintiffs’ claims rested on allegations of anticompetitive conduct stemming from a DOJ investigation of Mylan as well as multiple lawsuits brought by state attorneys general against generic-drug companies, including Mylan. The district court granted summary judgment for the defendants on all the plaintiffs’ claims, and the plaintiffs appealed. The Second Circuit affirmed the grant of summary judgment. With respect to EpiPen-related claims, the Second Circuit observed that the plaintiffs did not challenge the district court’s ruling that the plaintiffs had failed to adduce any evidence of scienter. Instead, the plaintiffs tried to argue that the scienter ruling did not apply to the EpiPen claims. The Second Circuit rejected this argument, however, finding that the “district court expressly considered each of the alleged misstatements […] and concluded that [the plaintiffs] failed to adduce sufficient evidence of scienter on any of them.” As for the generic-drug claims, the Second Circuit affirmed dismissal on loss causation grounds. Specifically, the court found that the alleged corrective disclosures proffered by the plaintiffs on appeal — a news article about the DOJ investigation, a public statement by President Trump about the need to reform generic-drug pricing practices, and court filings in the antitrust lawsuits involving the company — did not reveal any new nonpublic information and instead contained “merely […] ‘negative characterization of already-public information’” about Mylan.
Christiansen v. Spectrum Pharmaceuticals, Inc., 2024 WL 246020 (S.D.N.Y. Jan. 23, 2024)
The plaintiff alleged that Spectrum Pharmaceuticals, Inc., and certain of its executive officers violated Sections 10(b) and 20(a) of the 1934 Act for allegedly false and misleading statements about the company’s progress in gaining FDA approval of its new lung cancer treatment, poziotinib. The court granted in part and denied in part the defendants’ motion to dismiss. The court dismissed the plaintiff’s claims with respect to a majority of the challenged statements, finding that the statements about dosage optimization were not misleading because they were opinions and the defendants did not have an affirmative duty to disclose FDA’s reservations about dosage optimization. Similarly, the court found that the defendants’ disclosures about the risks of achieving FDA approval for poziotinib were not false or misleading because that risk had not yet materialized at the time the statements were made. And the court found the statement that Spectrum was “on the cusp of […] two FDA approvals” was not actionable because projections about the likelihood of FDA approval are “forward-looking statements” and thus fell within the PSLRA’s safe harbor provision. The court, however, found that the plaintiff had plausibly alleged claims with respect to two of the challenged statements. First, the court found that the plaintiff adequately alleged that a statement that Spectrum and FDA were aligned on the dosage regimen for a study involving poziotinib was potentially actionably false because the plaintiff alleged that FDA officials had specifically requested that Spectrum provide more data for FDA to optimize the dosage. Second, the court found that statements creating an allegedly false impression that patients had already been enrolled in the study were actionable. The court further found that the plaintiff had adequately pleaded scienter against Spectrum and two of the individual defendants with respect to those statements because the individuals were alleged to be aware from their meetings with FDA that FDA disagreed with Spectrum’s proposed dosing regimen and the company had yet to enroll any patients in its poziotinib study. But the court dismissed all claims against one of the individual defendants, Spectrum’s CFO, because the plaintiff failed to allege any specific facts that he knew or had access to information that contradicted the potentially actionable statements.
Merritt v. Molecular Partners AG, 2024 WL 495140 (S.D.N.Y. Feb. 5, 2024)
The plaintiff alleged that Molecular Partners AG violated Sections 11 and 15 of the 1933 Act by making false and misleading statements in its initial public offering (IPO) registration statement. Specifically, the plaintiff claimed that the registration statement omitted the fact that certain of the company’s patents were nearing expiration and that a competitor’s drug trials were further along, which rendered a licensing agreement with Amgen less valuable to Amgen and, therefore, meant the agreement was “in jeopardy.”
In dismissing the plaintiff’s claims, the court reviewed each of the challenged statements and determined that the alleged omissions did not render any of the statements misleading. First, the court held that certain opinion statements were not actionable because they did not imply facts that could be proven false. Namely, they did imply facts about the risk that the agreement with Amgen would be terminated — especially given that the defendants disclosed that the agreement could be terminated “in its entirety” at Amgen’s “convenience.” Likewise, the court found that, “whether read in isolation or in context,” these opinion statements implied nothing about the success of trials with Amgen relative to the success of trials by its competitor and, therefore, could not be a basis for liability. Next, the court rejected the plaintiff’s argument that statements regarding the terms of the Amgen agreement were misleading, including statements about planned trials and that the agreement could be terminated at Amgen’s convenience, by failing to mention that the agreement was in jeopardy. The court reasoned that “the complaint fails to plausibly allege that the Amgen agreement was in fact in jeopardy at the time the registration statement became effective,” highlighting that Amgen did not terminate the agreement for a year after the IPO, and the complaint does not allege that Amgen terminated the agreement because of the competitor’s trials. The court also held that those statements could be misleading only if there was something unique about the threat from the competitor that was not captured by the registration statement’s warning that Molecular Partners “face[s] significant competition” — something the plaintiff failed to allege. Finally, the court analyzed each of the allegedly misleading forward-looking statements, noted that they were accompanied by specific cautionary language, and for similar reasons found they were not misleading.
San Antonio Fire & Police Pension Fund v. Dentsply Sirona Inc., 732 F. Supp. 3d 300 (S.D.N.Y. 2024)
The plaintiffs alleged that Dentsply Sirona Inc., the world’s largest manufacturer of professional dental products and technologies, and certain of its executives, including its CEO, CFO, and chief accounting officer (CAO), violated the 1934 Act by making false and misleading statements regarding Dentsply’s inventory, supply chain, product quality, and overall financial health. The plaintiffs alleged that during the COVID-19 pandemic, a time when dentist offices shut down and demand for professional dentist products fell, Dentsply artificially inflated sales by forcing its distributors to take on more inventory (i.e., channel stuffing). When dentist service demand picked back up, Dentsply reported disappointing earnings and announced an internal investigation that led to restatements of its previous earnings. The court granted the defendants’ motion to dismiss in part and denied it in part. While some of the alleged misstatements were inactionable (e.g., as puffery, “the supply-chain team has done a great job of managing and handling risks”), the court concluded other statements were definite and verifiable and, therefore, plausibly actionable (e.g., “we feel good that we have adequate supply”). The court went on to find that the plaintiffs adequately pleaded scienter as to Dentsply’s CEO and CFO but not its CAO. The complaint drew a direct link between the alleged fraud and the CEO’s and CFO’s compensation, which supported a fraudulent motive. The court found that the plaintiffs also sufficiently alleged that the CEO and CFO had actual knowledge of the alleged misleading nature of Dentsply’s statements. The court cited the specificity of the CEO’s and CFO’s statements on topics such as inventory levels, distribution partners, and Dentsply’s supply chain. As the court explained, “[t]he specificity of [the defendants’] statements […] is strong circumstantial evidence that [they] were receiving some form of specific information on [these topics].” The court also held that allegations that the CEO and CFO imposed outlandish sales targets, silenced critics, and muddied internal controls contributed to the scienter inference, as did the timing and circumstances of their departures from Dentsply (e.g., Dentsply did not confirm that the CEO was fired without cause). On the other hand, the court concluded that none of the scienter allegations applied to the CAO, and so the inference was weak. As a result, the court granted the defendants’ motion to dismiss as to certain statements and the CAO and denied it as to other statements and the CEO and CFO.
In re Y-mAbs Therapeutics, Inc., Securities Litigation, 2024 WL 451691 (S.D.N.Y. Feb. 5, 2024)
The plaintiff alleged that Y-mAbs Therapeutics, Inc., and certain of its officers violated Sections 10(b) and 20(a) of the 1934 Act and SEC Rule 10b-5 by making misleading statements about the timeline for and prospects of I-omburtamab, a potential therapy developed by Y-mAbs to treat pediatric patients with neuroblastoma. Y-mAbs initially submitted a Biologics License Application (BLA) regarding I-omburtamab to FDA in 2020. FDA refused to file this first BLA, noting that Y-mAbs did not provide sufficient evidence that I-omburtamab was safe and effective. Over the next several years, Y-mAbs made statements about the timeline for filing the revised BLA and its progress toward that submission, expressed confidence that Y-mAbs’ new BLA would address FDA’s concerns, and discussed its clinical data for I-omburtamab. In early 2022, while still waiting for feedback from FDA regarding certain data, Y-mAbs submitted a new BLA for I-omburtamab. Six months later, FDA rejected the submission of the second BLA and released a briefing document highlighting issues with Y-mAbs’ second BLA and noting FDA had repeatedly warned Y-mAbs of those issues. The plaintiff, a Y-mAbs stockholder, brought this litigation in response. The court granted in part and denied in part the defendants’ motion to dismiss. The court held that statements about the timing of the BLA resubmission were protected forward-looking statements and must be dismissed. Statements about the progress of the BLA submission (e.g., statements that Y-mAbs was “optimistic” about approval) were nonactionable statements of opinion, not directly contradicted by any of the facts pleaded. Y-mAbs’ statements interpreting its clinical data were similarly not materially misleading because none of the statements claimed that FDA had similar interpretations and Y-mAbs disclosed FDA’s concerns about the data. However, the court concluded that certain statements about FDA’s feedback were actionable. More concrete statements that Y-mAbs was putting together a BLA package that satisfied FDA’s concerns or that Y-mAbs had “all the information that we need” were plausibly actionable and misleading. Those statements were directly contradicted by the plaintiff’s allegations that FDA had told Y-mAbs that it had outstanding concerns about Y-mAbs’ datasets. The court also concluded that the plaintiff had adequately alleged scienter with regards to these alleged misleading statements because Y-mAbs had knowledge of FDA’s alleged concerns.
Pitman v. Immunovant, Inc., 2024 WL 1342737 (E.D.N.Y. Mar. 29, 2024)
The plaintiff alleged that Immunovant, Inc., a related entity of Roivant Sciences Ltd., and certain of its executive officers violated Sections 11, 12(a)(2), and 15 of the 1933 Act and Sections 10(b) and 20(a) of the 1934 Act. The plaintiff also asserted claims against the underwriters of Immunovant’s de-SPAC transaction for alleged violations of Sections 11 and 12(a)(2) of the 1933 Act. The plaintiff alleged that the defendants made material misstatements and omissions, including in the offering documents for Immunovant’s de-SPAC transaction, concerning the development of its drug IMVT-1401 for the treatment of autoimmune diseases. The court dismissed the plaintiff’s claims in their entirety, finding that the allegations at their core were founded on little more than a fundamental disagreement as to the interpretation of scientific data. Specifically, the plaintiff contended that the defendants should have placed different weight upon the cholesterol risks associated with IMVT-1401 and thus made different choices concerning trial design. Under controlling Second Circuit law, the court held that this was not a valid basis for securities law claims. The court also held that certain statements in the de-SPAC offering documents that Immunovant’s trials complied with FDA’s regulations on “good clinical practice” were nonactionable statements of opinion. Further, the court found that the plaintiff’s 1934 Act claims failed for the additional reason that the plaintiff did not adequately plead scienter. The court reasoned that the plaintiff’s disagreement with the defendants’ interpretation of the relevant scientific data was insufficient to support an inference of recklessness. And the court likewise rejected the plaintiff’s alternative scienter theory that the defendants deliberately sought to inflate the value of Immunovant’s stock price because the plaintiff’s theory was unsupported by any specific factual allegations of motive or opportunity.
Kempen International Funds v. Syneos Health, Inc., 2024 WL 1805011 (S.D.N.Y. Apr. 25, 2024)
The plaintiffs alleged that Syneos Health, Inc., a clinical-research company that assists in pharmaceutical trials, and certain of its executive officers violated Sections 10(b) and 20(a) of the 1934 Act and SEC Rule 10b-5 by misreporting metrics on the number of clinical trials in its pipeline and making misleading statements about the health of the business. The court granted the defendants’ motion to dismiss because the complaint was not pleaded with particularity. Instead, it was an example of a “puzzle pleading” because it contained block quotations of Syneos’ allegedly misleading statements and a list of adverse facts that were allegedly known by Syneos, leaving the court “to search the long quotations in the complaint for particular false statements, and then determine on its own initiative how and why the statements were false and how other facts might show a strong inference of scienter.” Because the alleged class period covered several years of mergers and financial filings, absent the plaintiffs’ specific allegations of when the misstatements occurred or when Syneos knew about them, the court was unable to evaluate whether the statements were plausibly false or misleading or whether there was a strong inference that the defendants acted with scienter.
Fernandes v. Centessa Pharmaceuticals PLC, 2024 WL 3638254 (S.D.N.Y. Aug. 2, 2024)
The plaintiffs alleged that Centessa Pharmaceuticals plc, certain of its officers, and the underwriters of its IPO violated Sections 11 and 15 of the 1933 Act. The plaintiffs alleged that Centessa’s IPO registration statement contained false and misleading statements concerning its drug product lixivaptan, which was designed to treat autosomal dominant polycystic kidney disease (ADPKD). Specifically, the plaintiffs challenged certain statements regarding lixivaptan’s safety profile relative to the only other FDA-approved drug for the treatment of ADPKD, tolvaptan, and lixivaptan’s clinical and commercial prospects. The court, however, dismissed all of the plaintiffs’ claims against the challenged statements because they failed to read those statements in the full context of the registration statement. Virtually all the challenged statements were nonactionable statements of opinion and/or forward-looking statements that were appropriately qualified by meaningful cautionary language across more than 80 pages of risk disclosures in the registration statement. The court also found that the plaintiffs failed to allege any actionable omissions because the registration statement included many of the facts concerning lixivaptan’s clinical studies that the plaintiffs alleged to be missing. And the remaining supposed omissions were not actionable because they were based solely on the plaintiffs’ critiques of Centessa’s study designs and not any actual mischaracterization of the lixivaptan studies or any other facts concerning the drug.
In re Evolus Inc. Securities Litigation, 2024 WL 4306786 (S.D.N.Y. Sept. 26, 2024)
The plaintiffs alleged that Evolus Inc., the manufacturer of Jeuveau, a competitor of Botox, and certain of its executive officers violated Sections 10(b) and 20(a) of the 1934 Act and SEC Rule 10b-5 based on allegedly false and misleading statements about the merits of a complaint to the U.S. International Trade Commission (ITC) that Jeuveau was manufactured using proprietary information stolen from Botox’s manufacturer. The plaintiffs also brought a claim for insider trading under Section 20A of the 1934 Act against Evolus’ parent company, Alphaeon Corporation, based on its sale of Evolus shares during the alleged class period.
The court dismissed the plaintiffs’ claims against Evolus and its executives, finding that none of the statements challenged by the plaintiffs was actionably false or misleading. First, the court rejected the plaintiffs’ challenge to the defendants’ statements expressing confidence in Evolus’ legal position in the ITC litigation, finding that the anonymous statements were insufficient to plead fraud with particularity under Rule 9(b). Further, the court found that the statements from identified speakers were subjective and forward-looking evaluations and thus were not actionably false or misleading. Second, the court found that the company’s description of Jeuveau as its “proprietary” product could have a variety of different meanings in this context, such as “unique,” “legally protected,” or subject to a license, and thus was too vague to be actionable. Third, the court dismissed the plaintiffs’ claims challenging Evolus’ statements about the “competitive strengths” of Jeuveau in light of the ITC litigation, which the court found implausible because Evolus disclosed the ITC litigation in the same SEC filings as the contested statements. Finally, the court concluded that Evolus’ statements that the company’s “original founder” had “developed” Jeuveau were not actionable because Evolus disclosed that it licensed Jeuveau from another company, Daewoong Pharmaceutical, and did not otherwise falsely represent its role in the development of Jeuveau.
In addition, the court found that the plaintiffs had not adequately pleaded scienter as to any defendant. Although the plaintiffs claimed that the defendants’ stock sales established motive to commit fraud, the court found that the stock sales were not sufficiently suspicious or unusual to support a strong inference of scienter, particularly because Evolus’ CEO, who made or authorized most of the contested statements, did not trade during the class period. Additionally, the court found that the plaintiffs failed to establish scienter through conscious misbehavior or recklessness because the defendants were prohibited from reviewing discovery in the ITC litigation by a protective order and thus had not seen evidence concerning the supposedly contested origins of Jeuveau. Similarly, as for the insider trading allegations under Section 20A, the court found that the plaintiffs had not adequately pleaded that any representatives of Alphaeon were in possession of material nonpublic information from the ITC litigation at the time it sold Evolus stock.
Roofers Local No. 149 Pension Fund v. Amgen Inc., 2024 WL 4354809 (S.D.N.Y. Sept. 30, 2024)
The plaintiff alleged that Amgen Inc. and certain of its officers violated Sections 10(b) and 20(a) of the 1934 Act and SEC Rule 10b-5 by concealing from investors the magnitude of Amgen’s back-tax liability and penalties owed to the IRS. This action arose following an IRS investigation and audit into Amgen’s practice of shifting Amgen’s US profits to subsidiaries with lower tax rates in Puerto Rico, a practice known as transfer pricing. Amgen’s use of transfer pricing allegedly helped the consolidated entity benefit from an extremely low effective tax rate, which in turn drastically increased the company’s net income prior to and during the class period. After yearslong examinations, the IRS determined that Amgen underpaid taxes for those six years by $8.7 billion and imposed $2 billion in penalties on Amgen. While Amgen had previously disclosed the IRS audit and warned generically that it could have a substantial impact on the company, when it disclosed that the IRS sought to recover $10.7 billion (more than an entire year of the company’s profits), Amgen’s stock price plummeted.
The court denied dismissal, concluding that the plaintiff plausibly alleged that the defendants’ failure to disclose the specific amount of potential liability the company faced from the IRS could have misled Amgen investors by failing to sufficiently apprise them of the severity of the risks Amgen faced. The court explained that “given the sheer size of the potential liability Amgen was facing, Defendants’ vague characterizations of the amounts the IRS was seeking as ‘significant’ and ‘substantial’ and potentially ‘material’ rendered its disclosure of the tax dispute neither ‘clear’ nor ‘complete.’” Conversely, the court rejected the plaintiff’s contention that Amgen’s statements in the “Contingencies” section of its annual and quarterly SEC filings that certain legal proceedings “[had not] progressed sufficiently […] to enable [Amgen] to estimate a range of possible loss” for recognition as a loss contingency was materially misleading in light of the IRS dispute. It reasoned that these statements were not clearly related to the IRS dispute and, paired with Amgen’s general disclosures, meant that, in context, “no reasonable investor could thus have been left with the impression that the IRS was not seeking a quantifiable amount of relief.”
Meyer v. Organogenesis Holdings, Inc., 727 F. Supp. 3d 368 (E.D.N.Y. 2024)
The plaintiffs alleged that Organogenesis Holdings, Inc., and certain of its officers violated Sections 10(b) and 20(a) of the 1934 Act, alleging that after Organogenesis lost revenue following the expiration of pass-through status for two of its products, it began an illegal marketing scheme to maintain sales. In particular, the plaintiffs alleged that the defendants, to artificially inflate revenues, manufactured a “spread” between the amount that Organogenesis charged physicians and the amount of Medicare reimbursement per product. The court granted the defendants’ motion to dismiss with leave to amend, finding that the plaintiffs failed to adequately plead falsity and facts supporting a strong inference of scienter. On falsity, the court found that the plaintiffs had not alleged that any statements were objectively false or inaccurate, and instead found that the statements were far too general to trigger any duty to disclose the alleged scheme or were nonactionable statements of corporate optimism (e.g., “we are the gold standard of compliance,” “Organogenesis is well-positioned”). Organogenesis’ risk disclosures also sufficiently warned investors that changes in reimbursement could affect future financial performance. As to scienter, the court rejected the plaintiffs’ allegations with respect to stock sales and funding, finding no inference of scienter where sales were made pursuant to Rule 10b5-1 trading plans and spread out throughout the class period or on the basis of motivations “possessed by virtually all corporate insiders.” The court found that the confidential witness allegations also could not support an inference of scienter because the witnesses failed to identify any information that contradicted the alleged misstatements.
Stadium Cap. LLC v. Co-Diagnostics, Inc., 2024 WL 456745 (S.D.N.Y. Feb. 5, 2024)
The plaintiff alleged that Co-Diagnostics, Inc., and certain of its officers violated Sections 10(b) and 20(a) of the 1934 Act and SEC Rule 10b-5 for making misleading statements regarding the financial health of the business in the wake of inflated COVID-19 revenues. The plaintiff alleged that Co-Diagnostics and its officers failed to disclose that sales had practically cratered during the class period, until that information was finally disclosed in Co-Diagnostics’ Form 10-Q for the second quarter of 2022.
The court granted in part and denied in part Co-Diagnostics’ motion to dismiss. First, it found at least some of Co-Diagnostics’ statements were misleading because they warned about future risks but failed to disclose that those risks had already come to pass; were not statements of opinions or puffery because they were responses to direct questions about whether sales had declined; and were not forward-looking or protected by the PSLRA’s safe harbor because they described present conditions and were not accompanied by adequate cautionary language. The plaintiff also adequately alleged a strong inference of scienter because its executives had access to Co-Diagnostics’ books and records and had made statements on earnings calls about being able to monitor daily demand. Moreover, under the core operations doctrine, those individuals were likely to have known that demand for their products had fallen substantially.
In re Bristol-Myers Squibb Co. CVR Securities Litigation, (S.D.N.Y. Feb. 29, 2024)
The plaintiffs alleged that Bristol-Myers Squibb (BMS) Company and certain of its executive officers violated Sections 10(b) and 20(a) of the 1934 Act and SEC Rule 10b-5 on behalf of purchasers and/or acquirers of contingent value rights (CVRs) issued by BMS in connection with its 2019 acquisition of Celgene Corporation. Holders of the CVRs were entitled to $9 per CVR, provided that certain conditions were met, namely that three drug candidates that Celgene had been developing at the time of the transaction received FDA approval by predetermined milestone deadlines. After the first drug product, lisolisol-cel, failed to receive FDA approval by the applicable deadline, the plaintiffs sued on the theory that the defendants’ statements about their efforts to meet the milestone deadlines and the likelihood of triggering the CVRs were false and misleading because, in fact, “Bristol intended to slow-roll the FDA application process […] so that it would miss at least one FDA milestone and avoid making the $6.4 billion CVR payment.”
The court dismissed the plaintiffs’ claims for a second time, holding that the plaintiffs failed to adequately plead scienter. First, the court found that the plaintiffs failed to allege that the defendants had either motive or opportunity because they could not show that the defendants accrued any actual benefit from the supposed fraud. None of the defendants purchased BMS stock during the alleged class period, which the court reasoned was necessary to substantiate the plaintiffs’ theory that the defendants knew “all the while” that BMS would not make the CVR payment and thus the market was underpricing BMS stock. And the court found that it was economically irrational for BMS to intentionally delay the FDA approval process to avoid the CVR payout, because this would inevitably lead to litigation seeking equivalent damages for a breach of the CVR agreement. Ultimately, the court concluded that the plaintiffs’ argument that the defendants had a motive to keep BMS stock high, standing alone, was insufficient to establish scienter. Second, the court concluded that the plaintiffs failed to allege strong circumstantial evidence of conscious misbehavior or recklessness. The plaintiffs argued that the defendants knew or should have known of FDA approval failures involving lisolisol-cel by virtue of their senior positions at BMS and their membership on certain oversight committees. However, the court observed that generic allegations regarding the defendants’ positions or committee memberships were not enough to give rise to an inference of recklessness. Likewise, the court rejected the plaintiffs’ confidential witnesses and expert allegations that the defendants “would have been aware of underlying issues regarding the FDA approval process,” because those allegations did not speak to the mental state or knowledge of the defendants specifically.
In re Spero Therapeutics, Inc., Securities Litigation, 2024 WL 4593422 (E.D.N.Y. Oct. 28, 2024)
The plaintiffs alleged that Spero Therapeutics, Inc., and certain of its officers and directors violated the 1934 Act by allegedly making materially misleading statements about the prospects for tebipenem, Spero’s antibacterial oral drug candidate designed to treat complicated urinary tract infections. Spero conducted a Phase 3 clinical trial for tebipenem that supported Spero’s new drug application (NDA) for tebipenem. Ultimately, however, in May 2022, “based on the FDA’s feedback during a Late Cycle Meeting […] regarding the NDA” and FDA’s analysis of the Phase 3 trial, “Spero announced that it would immediately defer plans for the commercial launch of” tebipenem. This suit followed. The defendants filed a motion to dismiss, which the court granted. The court found that the plaintiffs failed to sufficiently allege scienter. The court noted that “the threshold for scienter is ‘near certainty’ that a drug will not be approved.” The court held that the complaint’s allegations did not show that. Instead, the court explained, the allegations suggested that the “Defendants were aware of some risk that the drug would not be approved, but ‘some’ risk is a far cry from near certainty.” The court also rejected the plaintiffs’ argument “that the timing of insider transactions and increases in executive compensation support an inference of scienter” because “none” were “executed between March and May 2022, the period during which it would have been arguably ‘unusual’ for an insider to make trades.”
In re BioLineRx Ltd. Securities Litigation, 2024 WL 3409800 (D.N.J. Jul. 15, 2024)
The plaintiffs alleged that BioLineRx Ltd. and two of its executives violated Sections 10(b) and 20(a) of the 1934 Act and SEC Rule 10b-5. In September 2022, BioLineRx, a foreign private issuer, filed a Form 6-K with the SEC, accompanied by a press release that it was issuing and selling 13.6 million American depositary shares (ADSs) at a discount of almost 30% to raise $15 million for its upcoming commercial launch. In response to this press release, BioLineRx’s ADS price fell by 34%. The plaintiffs, who had previously purchased ADS shares, alleged that the company’s prior statements that they had sufficient capital were materially misleading. The court dismissed the case against all defendants. The court concluded that the plaintiffs did not sufficiently allege any material misrepresentation made by the defendants. The court reasoned that the plaintiffs erred in assuming the defendants’ announcement to raise capital meant that the company was in immediate need of funds. That assumption, the court held, was insufficient to meet the heightened pleading standards under the PSLRA. The court went on to state that even if the defendants’ statements about having sufficient capital were held to be misleading, their beliefs about the sufficiency of BioLineRx’s capital would likely fall under the forward-looking statement safe harbor of the PSLRA. The court did grant the plaintiffs leave to file an additional amended complaint.
In re Celgene Corporation, Inc. Securities Litigation, 2024 WL 3503486 (D.N.J. Jul. 23, 2024) and In re Celgene Corporation, Inc. Securities Litigation, 2024 WL 4047674, (D.N.J. Sept. 4, 2024)
The plaintiffs brought a putative securities fraud class action against Celgene Corporation, Inc., and three of its executives for alleged violations of the 1934 Act. The plaintiffs alleged Celgene made materially misleading statements regarding the completeness of its NDA package for its drug candidate ozanimod. The plaintiffs alleged that, externally, Celgene indicated that submittal of the NDA was “on track” and imminent but, internally, management was aware of serious deficiencies in the NDA — including the discovery of metabolites in the drug product that needed further investigation. Plaintiffs asserted that those alleged deficiencies were later revealed through FDA’s prompt rejection of the NDA, precipitating a stock drop.
In a pair of decisions, the court first granted summary judgment as to the individual defendants. While the plaintiffs continued to press that the company’s COO was liable for certain statements contained in company press releases, the court concluded he was not the “maker” of those statements under Janus Capital Group, Inc., et al. v. First Derivative Traders, 564 U.S. 135 (2011). Because the plaintiffs had apparently abandoned their other claims against individuals, the motion was granted to them as well.
In its second decision, the court addressed the defendants’ motion for summary judgment on scienter grounds for 10 challenged statements, granting the motion in part and denying it in part. The court granted the motion as to the majority of the challenged statements because plaintiffs failed to plead contemporaneous facts showing that executives were aware of the deficiencies and believed those deficiencies would delay or otherwise doom FDA approval of the NDA. Instead, the record reflected that executives had been told the alleged deficiencies would not trigger any problems at all. However, the court denied summary judgment for three statements made close to the NDA submission because the record reflected that executives were discussing metabolite-related problems and expensive contingency plans should the NDA not be accepted. Combined, the court found this evidence gave rise to a strong inference of scienter.
Dang v. Amarin Corp. PLC, 2024 WL 4285900 (D.N.J. Sept. 25, 2024)
Plaintiffs alleged that Amarin Corporation plc and certain of its officers violated Section 10(b) and 20(a) of the 1934 Act by making material misstatements about one of the company’s pharmaceutical products, potential patent litigation surrounding this product, and the product’s financial prospects. The plaintiffs further alleged that these misstatements or omissions caused the artificial inflation in price of Amarin’s ADS, which dropped significantly, according to the plaintiffs, after Amarin lost the patent litigation. The court granted the defendants’ motion to dismiss in its entirety. The court addressed the sufficiency of the plaintiffs’ pleading for three categories of alleged misleading statements or omissions: the patent litigation, the product’s “unique” characteristics, and Amarin’s financial prospects following the results of a clinical trial. The court held that the plaintiffs failed to allege any actional misstatements or omissions regarding the patent litigation, because the defendants’ statements were all qualified nonactionable opinions (e.g., the litigation was going “very favorably,” or Amarin was “disappointed” in the court’s decision) instead of statements guaranteeing the outcome of the litigation. The court further held that statements regarding the product’s “unique” characteristics were not actionable because they were puffery (as “vague and general statements of optimism”). Finally, the court held that the statements regarding Amarin’s financial prospects (e.g., projections about the “potential for [the product] to help millions of patients”) were all nonactionable opinions as well for similar reasons. The court also considered whether the plaintiffs had adequately alleged scienter, ultimately concluding that they had not. While the plaintiffs had alleged that two defendants sold 89% and 65% of their total holdings, respectively, during the class period, the court took note that the class period stretched over two years, and the individual timing of the sales was not suspicious. While the court’s dismissal decision was without prejudice, the plaintiffs chose not to amend the complaint, and the case later terminated.
In re Sorrento Therapeutics, Inc. Securities Litigation, 97 F.4th 634 (9th Cir. 2024)
Plaintiffs alleged that Sorrento Therapeutics, Inc., a biopharmaceutical corporation, and its CEO and vice president violated Sections 10(b) and 20(a) of the 1934 Act and SEC Rule 10b-5 by making allegedly false and misleading statements that Sorrento had discovered a “cure” for COVID-19 in May 2020. Specifically, the plaintiffs alleged that the officers’ statements about an antibody discovery (e.g., “[w]e want to emphasize there is a cure. There is a solution that works 100 percent”; “if we have the neutralizing antibody in your body, you don’t need the social distancing”; and “if we were approved today, everyone who gets that antibody can go back to work and have no fear of catching COVID-19”) were false and misleading. The district court dismissed the plaintiffs’ first amended complaint, holding that the statements were “corporate optimism” and “puffery” when read within their surrounding context and thus not actionable under federal securities law. The district court also determined that the plaintiffs failed to establish a strong inference of scienter because Sorrento disclosed that the antibody was still preclinical and had not yet received FDA approval and the plaintiffs’ generalized assertions based on profit motive and the defendants’ stock sales were insufficient. The plaintiffs appealed. The Ninth Circuit subsequently affirmed dismissal on both fronts. The court held that the statements were not materially misleading because a fair reading of the statements makes clear that Sorrento had not developed an immediate cure; instead, the antibody needed to be subject to additional testing. As for scienter, the Ninth Circuit held that although the spike in stock price helped Sorrento’s financial situation, the plaintiffs did not make “the requisite showing of trading history necessary to raise an inference of scienter.”
Aramic LLC v. Revance Therapeutics Inc., 2024 WL 1354503 (N.D. Cal. Apr. 2, 2024)
The plaintiffs brought claims under the 1934 Act alleging that Revance Therapeutics Inc. and its CEO, CFO, and COO made false or misleading statements regarding the company’s attempt to secure FDA approval for its drug candidate DAXI. On November 25, 2019, Revance announced its submission of a BLA for DAXI, stating that it anticipated potential FDA product approval at the end of 2020. Due to the COVID-19 pandemic, FDA delayed its preapproval inspection of the DAXI manufacturing facility until July 2021. After completing the inspection, FDA provided Revance with a Form 483, containing five “inspectional observations” of potential noncompliance with manufacturing regulations. On October 15, 2021, FDA denied Revance’s BLA for DAXI. The court found a handful of Revance’s statements made following the inspection to be misleading. First, the court found a statement that Revance “may receive a Complete Response Letter or another response from FDA identifying deficiencies that must be addressed, rather than approval” was misleading because the company had already received Form 483 and did not disclose that those risks may already have come to pass. Second, the court found that statements touting Revance’s confidence in BLA approval post-inspection were misleading because, at the inspection, the FDA assessor allegedly told Revance’s COO that FDA recommended that the BLA be withheld for lack of commercial readiness. The court dismissed the complaint, however, because the plaintiffs failed to adequately allege a strong inference of scienter. The court rejected the plaintiffs’ allegations that the defendants knew of the existence of various deficiencies and, therefore, their statements about FDA approval were misleading, because the plaintiffs had not pointed to any contemporaneous evidence that the defendants believed that FDA approval was unlikely or would be delayed because of the deficiencies. Furthermore, the individual defendants were not alleged to have sold any Revance stock during the class period, which undermined an inference of scienter. The court also rejected liability for the CEO and CFO for failing to correct alleged misstatements made during conference calls that they attended because the plaintiffs failed to allege that they had ultimate authority over those statements. The court granted the motion to dismiss with leave to amend, giving the plaintiffs an opportunity to amend their scienter allegations.
Lowe v. Tandem Diabetes Care Inc., 2024 WL 1898473 (S.D. Cal. Apr. 30, 2024)
The plaintiffs alleged that Tandem Diabetes Care Inc. and two of its officers violated Sections 10(b) and 20(a) of the 1934 Act and SEC Rule 10b-5 by allegedly falsely downplaying to investors the impact of certain negative economic factors on company financial guidance at the beginning of 2022. Specifically, the plaintiffs contended that defendants were aware of three such economic “headwinds” relating to the COVID-19 pandemic and Tandem’s competitors throughout the class period but concealed the impact on sales that those conditions would have. In particular, the plaintiffs challenged statements touting Tandem’s ability to respond to market pressures (e.g., “we don’t see these economic headwinds as anything that would shift people’s mindset” and “we don’t think that this has anything to do with competitive dynamics”). The court dismissed the complaint with leave to amend, finding that the plaintiffs failed to adequately allege the falsity of the challenged statements or facts giving rise to a strong inference of scienter. The court first rejected the plaintiffs’ confidential witness allegations, finding them insufficiently pleaded to establish each witness’ reliability or personal knowledge. The court further held that the challenged statements were neither false nor misleading because the defendants failed to allege any contemporaneous facts showing the statements were false when made and instead repeatedly cautioned the market about the challenges Tandem was expected to face. The court also found that the plaintiffs failed to sufficiently plead scienter. The plaintiffs’ allegations that the officers wanted to “prevent the Company’s stock from declining” alone were insufficient to suggest any fraudulent intent, and the plaintiffs otherwise failed to allege any particularized facts that could support an inference of the defendants’ fraudulent intent.
Salzman v. ImmunityBio, Inc., 2024 WL 3100274 (S.D. Cal. June 20, 2024)
The plaintiff alleged that ImmunityBio, Inc., and its CEO, CFO, and chief scientific and medical officer violated Sections 10(b) and 20(a) of the 1934 Act and SEC Rule 10b-5 by misleading investors into believing that the company’s flagship product candidate, Anktiva, was manufactured by the company’s contract manufacturing organization, AGC Biologics, Inc., in compliance with industry standards. The plaintiff contended that the defendants knew that Anktiva’s manufacturing process was noncompliant and that it suffered from serious and persistent issues relating to recordkeeping, quality control, basic sanitation standards, and deviation management. The court found many of the challenged compliance-related statements to be potentially misleading. The court also found a strong inference of scienter based on the plaintiff’s allegations that the defendants were well-informed as to AGC’s manufacturing deficiencies through their quality agreement with AGC but consistently declined to inform investors. Further, because Anktiva was ImmunityBio’s lead product candidate, the court found it was reasonable to infer that the defendants would be closely involved in its FDA compliance and the defendants failed to disclose any Forms 483 or other deficiencies in Anktiva’s manufacturing process. The court refused to consider FDA’s approval of Anktiva in April 2024 as well as the $300 million investment by the company’s chief scientific and medical officer, which the defendants raised to counter the scienter allegations. The court thus denied the defendants’ motion to dismiss as to most of the challenged statements.
Pardi v. Tricida, Inc., 2024 WL 1056013 (N.D. Cal. Mar. 11, 2024)
The plaintiff alleged that Tricida, Inc., and its CEO violated Sections 10(b) and 20(a) of the 1934 Act after FDA denied Tricida’s NDA for veverimer, a drug for chronic kidney disease. The plaintiff alleged that, between 2018 and 2021, the company’s stock price was artificially inflated through false or misleading statements touting the success of clinical trials of veverimer and professing optimism about FDA’s review of its NDA. The court rejected that argument, finding that the challenged statements were mere opinions that the plaintiff failed to allege were insincere or objectively untrue. Moreover, the court acknowledged that the process of FDA review and approval is complex, involving a lengthy dialogue between companies and FDA, and “there is no general requirement under the securities laws for a company to engage in a rolling, communication-by-communication disclosure of every detail arising from the back-and-forth dialogue with the FDA throughout its complex review and approval process, or to adopt the FDA’s position as correct and share it with the public when discussing its product.” Thus, the fact that Tricida did not continuously convey FDA’s views and accept them as true was insufficient to plead falsity. However, the court declined to dismiss other claims arising from a factual statement made by the company’s CEO during an earnings call about the cancellation of an FDA Advisory Committee meeting. Relying on documents produced by FDA, the plaintiff alleged that the reason for the cancellation given by the CEO was false; rather, those documents showed that FDA believed there were too many problems with the company’s NDA to warrant an Advisory Committee meeting. The court further held that the plaintiff’s allegations that the CEO was party to extensive communications with FDA about its concerns and their potential impact on the meeting were sufficient to plead scienter because they “plausibly plead ‘an extreme departure from the standards of ordinary care, and which presents a danger of misleading buyers or sellers’ that was either known to [the CEO] or so obvious that he must have been aware of it.”
Strezsak v. Ardelyx Inc., 2024 WL 4194797 (N.D. Cal. Sept. 12, 2024)
The plaintiff alleged that Ardelyx Inc. and certain of its executive officers made false and misleading statements in violation of Section 10(b) of the 1934 Act and Rule 10b-5, concerning the company’s positive interactions with FDA, the success of clinical trials, the potential of its drug tenapanor to transform treatment for hyperphosphatemia, and the expectation of FDA approval. The plaintiff claimed that the defendants in fact knew that FDA had “significant concerns” about the magnitude of the treatment effect of tenapanor. In dismissing the plaintiff’s claims, the court found that the challenged statements were nonactionable statements of opinion, reasoning that the plaintiff failed to allege sufficient facts that the defendants did not hold the optimistic beliefs they expressed or that those beliefs were objectively untrue. The court explained that Ardelyx had no legal obligation to disclose “each detail of every communication with the FDA” because the company had not received feedback that contradicted its statements, presented risks that were “out of the ordinary,” or implicated a special challenge to approval. The court further explained that Ardelyx had, in fact, disclosed many of the allegedly omitted facts, including warnings that success depended on whether tenapanor’s efficacy profile satisfied FDA and that there was a higher likelihood of not obtaining FDA approval because the drug was first-in-class. The court also found that the plaintiff failed to adequately allege scienter, reasoning that “the FDA communications did not convey the type of serious and express concerns that could establish the knowing falsity of the challenged statements of opinion” and that simply failing to divulge all of the back-and-forth with FDA “alone cannot support an inference of scienter.” The court also rejected the plaintiff’s theory that suspicious stock sales supported scienter, holding that a sixfold increase in stock sales during the class period generally cannot support a “strong inference” of scienter absent some corroborating evidence. And it further held that simply alleging that tenapanor was “important” to Ardelyx did not give rise to a plausible inference of scienter.
Alger Dynamic Opportunities Fund v. Acadia Pharmaceuticals, Inc., 2024 WL 4647297 (S.D. Cal. Oct. 31, 2024)
The plaintiffs alleged that Acadia Pharmaceuticals, Inc., and its CEO violated Sections 10(b), 18(a) (i.e., providing cause of action for material misrepresentations in SEC filings on which plaintiffs actually relied), and 20(a) of the 1934 Act as well as California law for allegedly misleading investors regarding the likelihood of FDA approval of a supplemental NDA to expand the label of pimavanserin to treat dementia-related psychosis. The plaintiffs alleged that the defendants materially misled investors regarding the likelihood of FDA approval by suggesting that FDA had agreed to evaluate clinical trial results for the broader indication of dementia, when FDA later disclosed in a complete response letter denying approval that it had evaluated clinical trial results based on a dementia subtype. The court found that the plaintiffs’ alleged sufficient facts to support the inference that the defendants’ statements concerning agreement with FDA were potentially misleading “half-truths,” omitting that FDA had advised Acadia that “labeling would reflect the actual composition and response of the subjects enrolled” in the clinical trials. The court also found that the plaintiffs’ alleged facts gave rise to a strong inference of scienter under a core operations theory because, in the court’s view, the defendants were plausibly aware of the terms of any agreement with FDA and two of Acadia’s officers allegedly sold millions of dollars of stock, their first sales of Acadia stock ever, pursuant to SEC Rule 10b5-1 trading plans entered into after the company first received negative results from a clinical trial. The court denied the defendants’ motion to dismiss the plaintiffs’ Section 10(b) and 20(a) claims but did dismiss the plaintiffs’ Section 18(a) claim as untimely. In doing so, the court determined that the parallel class action asserting claims under Section 10(b) did not trigger American Pipe tolling for the Section 18 claim. The plaintiffs had also not pleaded actual reliance with the required specificity for the Section 18(a) claim to survive. The court also separately dismissed the plaintiffs’ state law claims as preempted under the Securities Litigation Uniform Standards Act of 1998.
In re DermTech, Inc. Securities Litigation, 2024 WL 4941026 (S.D. Cal. Dec. 2, 2024)
The plaintiffs brought claims under the 1934 Act alleging that the CEO and CFO of DermTech, Inc., engaged in fraudulent conduct and made false statements to conceal adverse information about the company’s financial condition. The plaintiffs challenged four categories of statements: statements regarding Medicare’s local coverage determination (LCD) of the DermTech Melanoma Test (DMT) patch; statements concerning the main drivers of the DMT’s average selling price; statements regarding DermTech’s revenue accounting adjustments and reclassifications; and DermTech’s new contracts at the start of 2023. The court found that the defendants’ statements that the final LCD for the DMT patch had “expanded coverage” to two tests when that expansion was limited to only 10% of patients were materially misleading and gave investors the impression that the “expanded coverage” applied to all patients. However, the court rejected the plaintiffs’ allegations that the defendants made misleading statements regarding the main drivers of the DMT patch’s average selling price, DermTech’s revenue accounting, or DermTech’s new contracts at the start of 2023. The court also found that the plaintiffs had not adequately alleged scienter because their allegations of suspicious stock sales by the CEO did not allege the percentage of shares sold and the $5.6 million in proceeds was not sufficient to raise suspicions; there was a compelling inference that the company’s at-the-market offerings were simply an effort to raise capital and not a motivation to commit fraud; certain statements about Medicare’s billing codes were consistent and did not support scienter; general allegations that the defendants had a motive to overstate new payer contracts to counter analyst estimates did not support a strong inference of scienter absent specific, contemporaneous facts of the defendants’ intent to defraud; the company’s publication of a restatement was not enough to find scienter; and confidential witness allegations failed to adequately allege that the witnesses were in a position to have the knowledge they professed. The court granted the defendants’ motion to dismiss without prejudice.
This informational piece, which may be considered advertising under the ethical rules of certain jurisdictions, is provided on the understanding that it does not constitute the rendering of legal advice or other professional advice by Goodwin or its lawyers. Prior results do not guarantee similar outcomes.
Contacts
- /en/people/b/birnbach-deborah

Deborah S. Birnbach
PartnerCo-Chair, Public M&A / Corporate Governance - /en/people/b/bullerjahn-caroline

Caroline H. Bullerjahn
PartnerCo-Chair, Complex Litigation & Dispute Resolution - /en/people/d/devoe-tucker

Tucker DeVoe
Partner - /en/people/a/andrews-lauren

Lauren Andrews Brandt
Associate - /en/people/b/blake-brendan

Brendan Blake
Associate - /en/people/d/dimaiti-drew

Drew DiMaiti
Associate